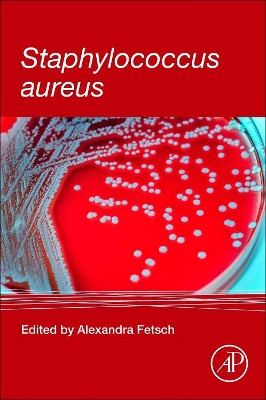
Staphylococcus aureus by Alexandra Fetsch 9780128096710

Filter By
- Book
- Qty in Cart
- Quantity
- Price
- Subtotal
-

Missing Microbes: How the Overuse of Antibiotics Is Fueling Our Modern Plagues by Martin J Blaser 9781250069276
RRP: £18.99Booksplease Price: £12.00Apologies but we at Booksplease don't have a full description for this book.Book InformationISBN 9781250069276Author Martin J BlaserFormat PaperbackPage Count 288Imprint Picador USAPublisher Picador USAWeight(grams) 249gDimensions(mm) 210mm * 140mm * 19mm -

Microbial Biotechnology by Kay Yeoman 9780198822813
Booksplease Price: £26.03Written primarily for students embarking on an undergraduate bioscience degree, this primer will introduce students to topics at the forefront of the subject that are being applied to probe biological problems, or to address the most pressing issues... -

Essential Microbiology Stuart Hogg (University of Glamorgan, UK) 9781119978909
RRP: £46.95Booksplease Price: £43.57Essential Microbiology 2nd Edition is a fully revised comprehensive introductory text aimed at students taking a first course in the subject. It provides an ideal entry into the world of microorganisms, considering all aspects of their biology... -

A Field Guide to Germs: Revised and Updated by Wayne Biddle 9781400030514
RRP: £20.00Booksplease Price: £14.44Apologies but we at Booksplease don't have a full description for this book.Book InformationISBN 9781400030514Author Wayne BiddleFormat PaperbackPage Count 240Imprint Anchor BooksPublisher Random House USA IncWeight(grams) 208gDimensions(mm) 203mm *... -

Clinical Microbiology by J. Keith Struthers 9781498786898
RRP: £48.99Booksplease Price: £44.67This concise, beautifully illustrated book provides a convenient introduction to the basic science of medical microbiology and how this relates to clinical practice. Expanded from the prize-winning first edition to cover virology and parasitology in... -

The antibacterial of Peganum harmala, muscle relaxant, hypnotic seeds by Thamer Tbeez 9783659542060
RRP: £27.31Booksplease Price: £26.20Apologies but we at Booksplease don't have a full description for this book.Book InformationISBN 9783659542060Author Thamer TbeezFormat PaperbackPage Count 52Imprint LAP Lambert Academic PublishingPublisher LAP Lambert Academic PublishingWeight(grams)... -

New Approaches to Prokaryotic Systematics: Volume 41 by Michael Goodfellow 9780128001769
RRP: £139.00Booksplease Price: £119.97Volume 41 of Methods in Microbiology is a methods book designed to highlight procedures that will revitalize the purposes and practices of prokaryotic systematics. This volume will notably show that genomics and computational biology are pivotal to... -

Advances in Applied Microbiology: Volume 132 Geoffrey M. Gadd 9780443345074
Booksplease Price: £111.57Advances in Applied Microbiology, Volume 132 presents a comprehensive exploration of the latest innovations in applied microbiology. The book delves into the diverse applications of microbiology across various industries, including agriculture, food... -

New Horizons in Halophilic Microbes and Their Enzymes Sunil Kumar Khare 9781032675282
RRP: £105.00Booksplease Price: £94.09This book presents a collection of the latest developments in halophile research over the last decade. The multi-themed volume captures emerging insights into halophilic microbes' diversity, physiology, and unique adaptation. The book emphasizes new... -

Microbial Solutions for Sustainable Agriculture Ghada Abd-Elmonsef Mahmoud 9781032863542
RRP: £130.00Booksplease Price: £115.67This book explains microbial roles for agricultural sustainability especially under climatic changes including role of microorganisms in sustainable agriculture. Major coverage entails role of microbial enzymatic roles in agriculture, microbial... -

Neglected Parasitic Zoonoses of Helminth Origin Debasis Bhattacharya 9781032670805
RRP: £130.00Booksplease Price: £115.97This book provides an in-depth analysis of neglected parasitic zoonoses of helminthic origin, offering a comprehensive understanding of their epidemiology, pathology, and implications for public health. With a focus on the One Health perspective, it... -

Anaerobes and Methanogenes Bhagwan Narayan Rekadwad 9781032798547
RRP: £125.00Booksplease Price: £111.65The book presents the complex realm of anaerobes and methanogens, which are microorganisms specialized in surviving in environments with very little or no oxygen. Anaerobes and methanogens play a vital role in many ecosystems ranging from the deep oceans... -

Hormone and Biofilm Interactions: Mechanisms and Applications Rina Rani Ray 9781032856186
RRP: £130.00Booksplease Price: £115.97This book comprehensively reviews the interplay between hormones and biofilms, uncovering the complex ways in which hormonal signals impact microbial communities and the formation of biofilms. It begins with an introductory overview of hormones and... -

New Research on Mycorrhizal Fungus by Ying-Ning Zou 9798886976373
RRP: £141.99Booksplease Price: £118.48Apologies but we at Booksplease don't have a full description for this book.Book InformationISBN 9798886976373Author Ying-Ning ZouFormat HardbackImprint Nova Science Publishers IncPublisher Nova Science Publishers Inc -

Clostridium difficile: Methods and Protocols by Peter Mullany 9781493957019
Booksplease Price: £123.10Clostridium difficile, a major nosocomial pathogen shown to be a primary cause of antibiotic-associated disease, has emerged as a highly transmissible and frequently antibiotic-resistant organism, causing a considerable burden on health care systems... -

Advances in Antiviral Drug Design: Volume 3 by E. De Clercq 9780762302017
Booksplease Price: £84.25Volume 3 of Advances in Antiviral Drug Design is keeping up with the recent progress made in the field of antiviral drug research and highlights five specific directions that have opened new avenues for the treatment of virus infections. First, the use... -

Ananthanarayan's Introduction to Medical Microbiology for GNM Students by Sathya Bhama 9789393330574
Booksplease Price: £17.17Apologies but we at Booksplease don't have a full description for this book.Book InformationISBN 9789393330574Author Sathya BhamaFormat PaperbackPage Count 212Imprint Universities PressPublisher Universities PressDimensions(mm) 250mm * 200mm * 50mm -

Microbiologia General - Nueva Edicion by Hans G Schlegel 9788428210300
Booksplease Price: £56.48Apologies but we at Booksplease don't have a full description for this book.Book InformationISBN 9788428210300Author Hans G SchlegelFormat PaperbackImprint OmegaPublisher Omega -

Microbiota. Los Microbios de Tu Organismo by Ignacio Lopez-Goni 9788416622535
Booksplease Price: £10.49Apologies but we at Booksplease don't have a full description for this book.Book InformationISBN 9788416622535Author Ignacio Lopez-GoniFormat PaperbackPage Count 336Imprint AlmuzaraPublisher AlmuzaraWeight(grams) 204gDimensions(mm) 188mm * 124mm * 18mm -

Bioprocess Engineering and Technology: Downstream Process and Plant Design Biswanath Bhunia 9780367675677
RRP: £130.00Booksplease Price: £115.97This book deals with the practical aspects in bioprocess plant design, project engineering, process economics, IPR, and biobusiness prospects related to bioprocess engineering.Bioprocess Engineering and Technology: Downstream Process and Plant Design... -

Bioprocess Engineering and Technology: Upstream Process Biswanath Bhunia 9780367675646
RRP: £130.00Booksplease Price: £115.67This book discusses the various cellular interventions that are required for the upstream processes in bioprocess engineering such as growth requirement of different cell types, their maintenance, and various recombinant strategies/tools available to... -

Innovative Biotic Stress Management Strategies in Crops Dinesh Singh 9781032631547
RRP: £120.00Booksplease Price: £107.33Crops suffer from biotic and abiotic stress during their growing period. Biotic stress in crops is caused by living organisms, specifically viruses, bacteria, fungi, nematodes, insects, arachnids, phanerogamic plants, and weeds. They directly deprive... -

Bioprocess Engineering and Technology: Fundamentals Biswanath Bhunia 9780367675622
RRP: £130.00Booksplease Price: £115.97This book introduces the reader to basics in both engineering and life sciences required for designing an optimal bioprocess system. Bioprocess Engineering and Technology: Fundamentals integrates life science topics such as cell physiology, microbiology,... -

Introductory Microbiology by D. Balchandar 9788189422783
RRP: £78.00Booksplease Price: £76.28The book is intended for college students, offering comprehensive information on the fundamental principles of microbiology. It is structured in a manner that facilitates the understanding of all basic concepts, principles, and contemporary trends in the... -

Microbial Diversity and its Applications by N. P. Singh 9789381450666
RRP: £87.00Booksplease Price: £84.81Microorganisms are entities that hold a unique position in the human perspective of life. They exhibit an extensive range of molecular and chemical diversity, which is fundamental to the functioning of ecosystems. These organisms are utilized for a... -

Illustrated Dictionary of Microbiology by S.V. Patel, B.A. Golakiya,�L.F. Akbari & Valentina V. Umrania 9788119215355
RRP: £82.00Booksplease Price: £78.53This book is the culmination of the efforts of experts in the field of microbiology who have been active over the past two decades. It is a comprehensive collection of terms and concepts related to microbiology, as well as its sister disciplines. The... -

Microbial Diversity and Its Applications by S.B.Barbudde ,R.Ramesh & N.P.Singh 9788119235117
RRP: £43.00Booksplease Price: £42.89Microorganisms hold a unique place in human perception of life. They encompass an extensive range of molecular and chemical diversity, which is fundamental to ecosystem processes.Microorganisms are utilized for a variety of purposes, such as food... -

Cyanobacteria: Antibacterial Activity by Purshotam Kaushik 9788190723770
RRP: £72.00Booksplease Price: £70.31The book commences with the fossil record of cyanobacteria, and offers a comprehensive treatment of the antibacterial activity of cyanobacteria, based on extensive research conducted by the author. Moreover, the book highlights various other aspects of... -

Sustainable Agriculture: A Vision for Future by B.K.Desai & B.T.Pujari 9789358870169
RRP: £49.00Booksplease Price: £48.56The promotion of alternative agricultural systems in India and other countries has caused significant confusion. Despite this, a vast amount of valuable information has been generated, which is scattered and difficult for readers to locate in one place... -

Pandemic Outbreaks in the Twenty-First Century: Epidemiology, Pathogenesis, Prevention, and Treatment by Buddolla Viswanath 9780323856621
RRP: £118.00Booksplease Price: £110.44In the past two decades, several pandemics have ravaged the globe, giving us several lessons on infectious disease epidemiology, the importance of initial detection and characterization of outbreak viruses, the importance of viral epidemic prevention... -

Advances in Applied Microbiology: Volume 63 by Allen I. Laskin 9780444531919
Booksplease Price: £109.66Published since 1959, Advances in Applied Microbiology continues to be one of the most widely read and authoritative review sources in Microbiology. The series contains comprehensive reviews of the most current research in applied microbiology. Recent... -

Hepatitis C in Developing Countries: Current and Future Challenges by Sanaa M. Kamal 9780128032336
RRP: £78.95Booksplease Price: £73.40Hepatitis C in Developing Countries: Current and Future Challenges explores the current state of HCV in several countries, including Africa, Asia and South America. It maintains a dedicated focus on the epidemiology, clinical patterns, virologic... -

Fundamentals of Viroid Biology by Charith Raj Adkar-Purushothama 9780323996884
RRP: £95.95Booksplease Price: £88.73Fundamentals of Viroid Biology provides a comprehensive introduction to emerging research on viroids and their biology. The book is organized into three parts, with sections that discuss historical perspectives as well as information on classifications,... -

Techniques for Downstream process for Biologic Drugs and Vaccines by Basanta Kumara Behera 9780443191572
RRP: £134.00Booksplease Price: £123.09Techniques for Downstream process for Biologic Drugs and Vaccines provides comprehensive technologies involved in processing postharvest broth to separate the target biological therapeutic products of extracellular or intercellular aspects in nature - to... -

COVID 19: Tackling Global Pandemics through Scientific and Social Tools by S. Chatterjee 9780323858441
RRP: £118.00Booksplease Price: £110.44Coronavirus disease 2019 (COVID-19) is an infectious disease caused by SARS-CoV-2. It was first identified in December 2019 in Wuhan, Hubei, China, and has resulted in an ongoing pandemic. As of July 2020, more than 13.8 million cases have been reported... -

Viruses: From Understanding to Investigation by Susan Payne 9780128031094
RRP: £97.99Booksplease Price: £91.36Viruses: From Understanding to Investigation provides students with a map for lifetime learning by presenting the definition and unique characteristics of viruses, including major topics, such as the virus lifecycle, structure, taxonomy, evolution,... -
Staphylococcus aureus by Alexandra Fetsch 9780128096710
RRP: £62.95Booksplease Price: £59.28Staphylococcus aureus provides information on food borne outbreaks of disease and their impact on human health. It is for anyone interested in the features of the pathogen, and its food safety aspects, as well as its prevalence and possible control and... -

Recent Developments in Applied Microbiology and Biochemistry by 9780128163283
RRP: £118.00Booksplease Price: £110.74Recent Developments in Applied Microbiology and Biochemistry provides a comprehensive treatment and understanding on application oriented microbial concepts, giving readers insights into recent developments in microbial biotechnology and medical,... -

Cyanobacteria: Antibacterial Activity by Purshotam Kaushik & Abhishek Chauhan 9788119072774
Booksplease Price: £36.27The book commences with a comprehensive examination of cyanobacterias fossil record. It offers an extensive analysis of the antibacterial properties of cyanobacteria, based on extensive research conducted by the author. The book also sheds light on other... -

Gene Therapy for Viral Infections by Patrick Arbuthnot 9780124105188
RRP: £104.00Booksplease Price: £96.29Gene Therapy for Viral Infections provides a comprehensive review of the broader field of nucleic acid and its use in treating viral infections. The text bridges the gap between basic science and important clinical applications of the technology,...
